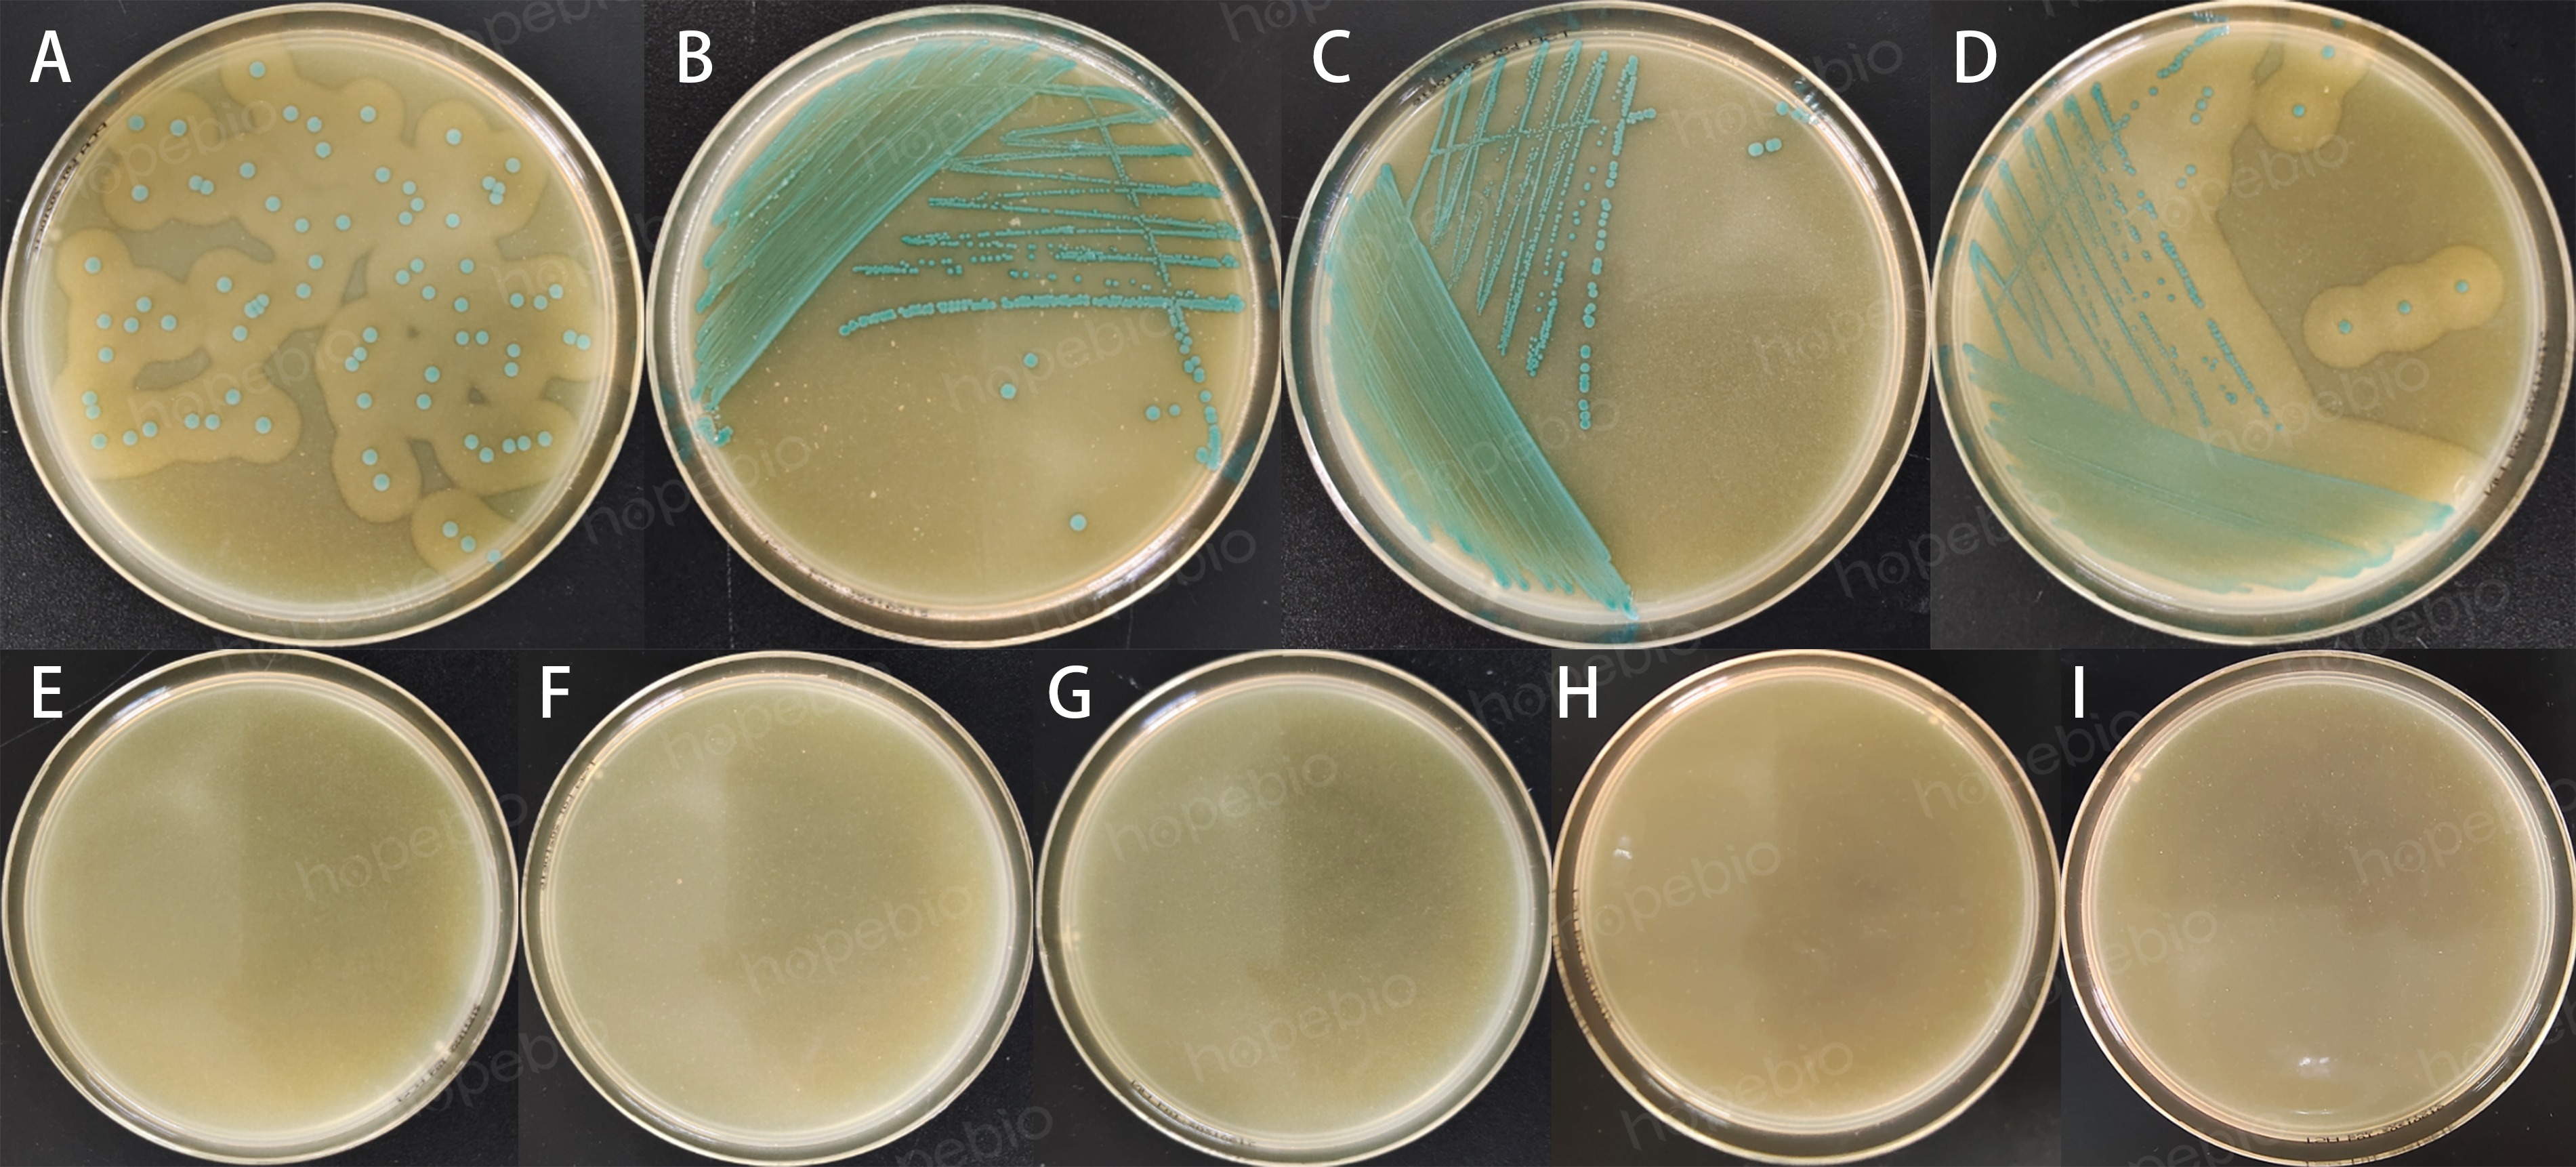

海博微信公众号
海博天猫旗舰店




一、单增李斯特氏菌简介:
单核细胞增生李斯特氏菌(Listeria monocytogenes)简称单增李斯特氏菌,广泛分布于自然界中,如土壤、水、污水和腐烂的植被中都有被发现,很容易污染食品,引起人的食物中毒。根据已发表的文献数据,可从巴氏杀菌奶、干酪、煮熟待吃的甲壳类、熏制的海鲜、三明治、新鲜水果和蔬菜及生贝类中检出。由于单增李斯特氏菌在低温条件下,可以缓慢繁殖,所以也可从冰激凌等冷冻食品中检出。因此,在食品卫生微生物检验中,必须加以重视。
二、李斯特氏菌显色培养基检验原理:
《GB 4789.30-2016 食品安全国家标准 食品微生物学检验 单核细胞增生李斯特氏菌检验》中,李斯特氏菌显色培养基为必选的选择性分离和计数培养基。
李斯特氏菌显色培养基是开云手机登录中心研制,可快速检测食品和药品中单增李斯特氏菌。蛋白胨提供氮源和氨基酸,氯化钠维持渗透压,琼脂是凝固剂,氯化锂抑制革兰氏阴性菌生长,抑菌剂抑制除李氏菌外的革兰氏阳性菌生长。根据单增李斯特氏菌生长代谢产生其特有葡萄糖甘酶及酯酶的特征,在培养基中加入相应的酶显色底物,单增李斯特氏菌在该培养基上生长,产生特有的菌落形态:菌落呈蓝绿色,其周围有一不透明环,从而使单增李斯特氏菌得到分离鉴别。
三、培养基配方:
基础培养基(g/L):
|
营养物质 |
70.0 |
|
显色剂 |
6.0 |
|
pH 7.2±0.2 25℃ |
|
李斯特氏菌添加剂6.0 g、李斯特氏菌抑菌剂(冻干粉)1 mL*5支
※ 此配方可以进行改良或增加营养成份以获得最佳的结果。
四、试验方法:
1. 配制培养基:称取基础培养基14.2 g加入180 mL蒸馏水,加热溶解并不停搅拌;另取1.2 g李斯特氏菌添加剂,加入20 mL无菌水,并加入一些玻璃球,不停振动1-2 min,使其混合均匀,将二者分别于121℃高压灭菌15 min。冷至50℃左右时,把李斯特氏菌添加剂加入基础培养基中,并加入复溶后的李斯特氏菌抑菌剂1支,混匀,倾入无菌平皿。使培养基的厚度约为2-3 mm,这样有利观察不透明环。
使用前,把制备好的培养基放置室温10-20分钟。
2. 按SN标准、GB标准、FDA标准、ISO标准或其它标准制备样品液;
3. 把样品液加入李氏增菌肉汤(LB1、LB2)中增菌;或把样品液和Half-Fraser增菌液按照1:10的比例混匀,30℃培养24小时;或其它增菌液中增菌培养;
4. 取一环增菌液划线接种到李斯特氏菌显色培养基上,36℃±1℃培养24-48小时。
五、试验结果判断:
接种以下质控菌株,放置37℃需氧培养24-48小时。
|
质控菌株 |
菌株编号 |
接种量 (CFU) |
参比或计 数培养基 |
方法 |
质控 结果 |
其他特征 |
|
单增李斯特氏菌 |
ATCC19115 |
20-200 |
TSA |
定量 |
PR≥0.5 |
蓝绿色菌落,带白色晕环 |
|
英诺克李斯特氏菌 |
ATCC33090 |
/ |
/ |
定性 |
/ |
蓝绿色菌落,无白色晕环 |
|
西尔李斯特氏菌 |
/ |
/ |
/ |
定性 |
/ |
蓝绿色菌落,无沉淀环 |
|
绵羊李斯特氏菌 |
/ |
/ |
/ |
定性 |
/ |
蓝绿色菌落,有沉淀环 |
|
大肠埃希氏菌 |
ATCC25922 |
/ |
/ |
半定量 |
G≤1 |
/ |
|
鼠伤寒沙门氏菌 |
ATCC14028 |
/ |
/ |
半定量 |
G≤1 |
白色小菌落 |
|
粪肠球菌 |
ATCC29212 |
/ |
/ |
半定量 |
G≤1 |
/ |
|
金黄色葡萄球菌 |
ATCC25923 |
/ |
/ |
半定量 |
G≤1 |
/ |
|
黑曲霉 |
ATCC16404 |
/ |
/ |
半定量 |
G≤1 |
/ |
图1 质控菌株在李斯特氏菌显色培养基上的生长情况
注:A:单增李斯特氏菌ATCC 19115;B:英诺克李斯特氏菌ATCC 33090;C:西尔李斯特氏菌ATCC 35967;D:绵羊李斯特氏菌ATCC 19119;E:大肠埃希氏菌ATCC 25922;F:鼠伤寒沙门氏菌ATCC 14028;G:粪肠球菌ATCC 29212;H:金黄色葡萄球菌ATCC 25923;I:黑曲霉ATCC 16404;
六、说明:
李斯特菌属的菌在此培养基上都是蓝绿色菌落,但只有单增李斯特氏菌和绵羊李斯特氏菌蓝绿色菌落周围有一层晕圈。单增李斯特氏菌与绵羊李斯特氏菌可以通过溶血环大小得到区分。因此,李斯特氏菌显色培养基效果明显优于PALCAM等传统培养基。
七、注意事项:
1. 贮存:制备好的固体平板保存于2-8℃,应避免光线直接照射。干燥培养基应放置于阴暗干燥处,保存温度2-8℃。
2. 失效:干燥培养基超过保质期、结块和颜色变化都不能使用。
3. 严格按照标签说明进行配制培养基,避免混合时培养基和添加剂温度过高导致平板出现絮状物。
相关视频:
相关标准:
GB 4789.30-2016 单核细胞增生李斯特氏菌检验 点击下载
相关产品:
注:本文属海博生物原创,未经允许不得转载。
下一篇:Bolton肉汤的简单介绍
